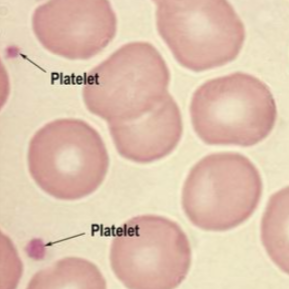

Platelets
1/21
Earn XP
Description and Tags
Flashcards based on some slides on Platelets. Other flashcards for Red Blood Cells, White Blood Cells, and a combination of all three can be found on my profile.
Name | Mastery | Learn | Test | Matching | Spaced |
|---|
No study sessions yet.
22 Terms
Platelets (thrombocytes)
Help initiate formation of blood clots; they close breaks in damaged blood vessels

Blood plasma
Transports nutrients, gases, vitamins, fluids, and maintains electrolytes and pH
Plasma proteins
Albumins
Globulins
Fibrinogens
Albumin
Plasma protein for blood pressure
Globulin
Plasma protein for antibody transport
Fibrinogen
Plasma protein for blood clotting
Multiple myeloma cancer
Cancer that affects plasma cells by crowding out healthy cells and producing harmful antibodies
Hemostasis
The process of stopping bleeding; involves coagulation and clotting of blood to seal site of damage

Hemostasis events
Vascular spasm
Platelet plug formation
Coagulation
Serotonin
A vasoconstrictor that aids in the vascular spasm
Thrombin
An enzyme in blood plasma that causes clotting by converting fibrinogen to fibrin
Coagulation
The thickening of blood to form a clot
Hematoma
Another name for a clot

Thrombus
An abnormally placed blood clot, such as within an artery or the heart

Embolus
When a clot within a vessel moves to another place, thus creating a blockage
Pulmonary embolism
An embolism (movement of blood clot) that moves to the lungs
Cerebral embolism
An embolism (movement of blood clot) that moves to the brain
Vitamin K
Can be injected to prevent deficiency bleeding in newborns
Hemophilia (bleeder’s disease)
Sex-linked recessive condition where blood does not clot
5 L
The amount of blood in the human body
0.5 L
The amount of blood taken in a donation
Blood donation uses
Purposes:
Hemophiliac clotting factor replacement
Sickle cell reduction
Injury or surgery blood replenishment